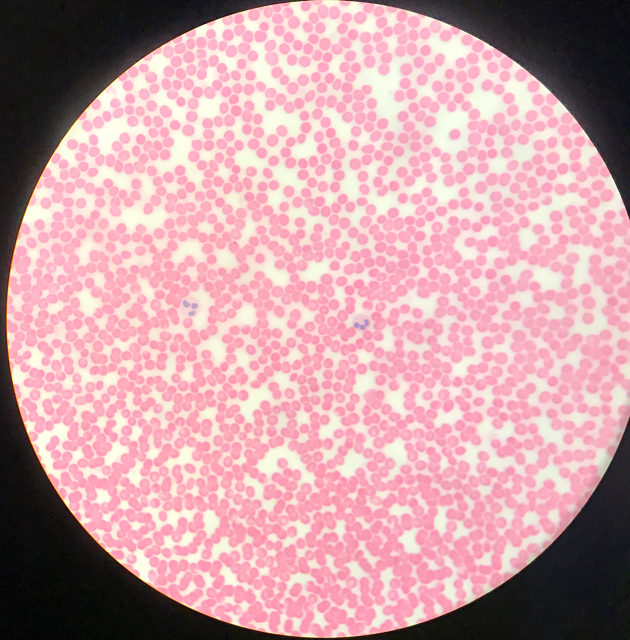

Termin 3 · Histologi
Histologi
Mikroskopisk anatomi för kroppens organsystem med fokus på homeostas. Här finner du bilder från mikroskop för att identifiera vävnader och strukturer.
Kurslitteratur
Kurslitteratur
Rekommenderad litteratur för Histologi. En god histologiatlas är ovärderlig för att lära sig identifiera vävnader:
- Ross & Pawlina: Histology: A Text and Atlas
- Junqueira's Basic Histology
Quiz
Quiz
Öva på alla histologipreparat från Termin 3
Referenssidor
Referenssidor
Detaljerade genomgångar av histologiska strukturer och kännetecken:
Epiteltyper
Översikt av olika epiteltyper och deras lokalisation
Blod & Luftvägar
Blodceller, luftvägar och lungans histologi
Urinvägar
Njurar, urinledare och urinblåsa
Lymfoid Vävnad
Thymus, lymfknutor, mjälte och MALT
Endokrina Organ
Hormonproducerande körtlar
Mag-tarmkanalen
GI-kanalens histologi från esofagus till colon
Tunga & Körtlar
Tunga, spottkörtlar och pankreas
Hjärta & Kärl
Kardiovaskulär histologi
Reproduktionsorgan
Manliga och kvinnliga reproduktionsorgan
Kursinnehåll
Kursinnehåll
Blod och Luftvägar
- Trachea och bronker
- Alveoler och gasutbyte
- Blodceller och blodutstryk
- Artärer, vener och kapillärer
Hjärta och Kärlsystem
- Hjärtmuskelns speciella egenskaper
- Elastiska och muskulära artärer
- Mikrocirkulation
- Lymfkärl
Digestionsorganen
- Mag-tarmkanalen
- Esofagus - skiktat skivepitel
- Ventrikel - körtlar och slemhinna
- Tunntarm - villi och kryptor
- Tjocktarm - gobletceller
- Accessoriska körtlar
- Lever - hepatocyter och portaltriad
- Gallblåsa
- Pankreas - exokrin och endokrin del
Njure och Urinvägar
- Nefron - glomerulus och tubuli
- Juxtaglomerulär apparat
- Ureter och urinblåsa
Endokrina System
- Hypofys - adeno- och neurohypofys
- Thyroidea - folliklar
- Parathyroidea
- Binjure - cortex och medulla
- Langerhanska öar i pankreas
Reproduktionsorgan
- Manliga
- Testis - seminifera tubuli
- Epididymis
- Prostata
- Kvinnliga
- Ovarium - folliklar
- Tuba uterina
- Uterus - endometrium faser
- Placenta
Preparat
Alla preparat
| Preparat | Namn | Kategori | Bilder |
|---|---|---|---|
| 3:1:1 | Trachea | Luftvägar | ![]() ![]() |
| 3:1:2 | Lunga | Luftvägar | ![]() ![]() ![]() ![]() ![]() ![]() ![]() ![]() |
| 3:1:3 | Blodkärl - Artär och ven | Blod och kärl | ![]() ![]() ![]() ![]() ![]() |
| 3:1:4 | Blodutstryk | Blod och kärl | ![]() ![]() ![]() ![]() ![]() ![]() ![]() ![]() ![]() ![]() |
| 3:2:1 | Hjärtmuskel | Hjärta | ![]() |
| 3:2:2 | Aorta | Kärl | ![]() ![]() ![]() |
| 3:2:3 | Elastisk artär | Kärl | ![]() |
| 3:2:4 | Muskulär artär | Kärl | |
| 3:2:5 | Kapillärer | Kärl | |
| 3:3:1 | Esofagus | Digestion | ![]() ![]() ![]() ![]() |
| 3:3:2 | Ventrikel | Digestion | ![]() ![]() ![]() ![]() ![]() ![]() ![]() ![]() ![]() |
| 3:3:3 | Duodenum | Digestion | ![]() ![]() ![]() ![]() ![]() ![]() ![]() ![]() |
| 3:3:4 | Jejunum | Digestion | ![]() ![]() ![]() |
| 3:3:5 | Ileum | Digestion | ![]() ![]() ![]() ![]() ![]() ![]() |
| 3:3:6 | Colon | Digestion | ![]() ![]() ![]() ![]() |
| 3:3:7 | Appendix | Digestion | ![]() ![]() ![]() ![]() ![]() ![]() ![]() ![]() |
| 3:5:1 | Lever (Hepar) | Digestion - Körtlar | ![]() ![]() ![]() |
| 3:5:2 | Gallblåsa (Vesica Fellea) | Digestion - Körtlar | ![]() ![]() ![]() ![]() |
| 3:5:3 | Pankreas | Digestion - Körtlar | |
| 3:6:1 | Njure - cortex och medulla | Urinvägar | ![]() ![]() ![]() ![]() ![]() ![]() ![]() ![]() ![]() ![]() |
| 3:6:2 | Ureter | Urinvägar | ![]() ![]() ![]() ![]() ![]() ![]() |
| 3:6:3 | Urinblåsa | Urinvägar | ![]() ![]() ![]() |
| 3:3:8 | Lingua (Tunga) | Digestion | ![]() ![]() |
| 3:3:9 | Lingua - Papilla Fungiforme | Digestion | ![]() ![]() |
| 3:3:10 | Lingua - Papilla Circumvallate | Digestion | ![]() ![]() ![]() |
| 3:3:11 | Glandula Sublingualis | Digestion | ![]() ![]() ![]() |
| 3:4:1 | Thymus | Lymfoid | ![]() ![]() ![]() |
| 3:4:2 | Lien (Mjälte) | Lymfoid | ![]() ![]() ![]() |
| 3:4:3 | Lymfnod | Lymfoid | ![]() ![]() ![]() ![]() |
| 3:4:4 | Peyerska Plaque | Lymfoid | ![]() ![]() ![]() |
| 3:4:5 | Tonsilla | Lymfoid | ![]() ![]() ![]() |
| 3:7:1 | Epifys | Endokrina | ![]() ![]() ![]() |
| 3:7:2 | Hypofys | Endokrina | ![]() ![]() ![]() ![]() |
| 3:7:3 | Thyroidea | Endokrina | ![]() ![]() ![]() ![]() ![]() |
| 3:7:4 | Parathyroidea | Endokrina | ![]() ![]() ![]() ![]() ![]() |
| 3:7:5 | Glandula Suprarenalis (Binjure) | Endokrina | ![]() ![]() |
| 3:8:1 | Testis | Reproduktion | ![]() |
| 3:8:2 | Epididymis | Reproduktion | ![]() |
| 3:8:3 | Ductus Deferens | Reproduktion | ![]() |
| 3:8:4 | Vesicula Seminalis | Reproduktion | ![]() |
| 3:8:5 | Prostata | Reproduktion | ![]() |
| 3:8:6 | Penis | Reproduktion | ![]() ![]() ![]() ![]() ![]() |
| 3:8:7 | Ovarium | Reproduktion | ![]() ![]() |
| 3:8:8 | Tuba uterina | Reproduktion | ![]() |
| 3:8:9 | Uterus | Reproduktion | ![]() |
| 3:8:10 | Cervix | Reproduktion | ![]() |
| 3:8:11 | Vagina | Reproduktion | ![]() |
| 3:8:12 | Mammae lakterande | Reproduktion | ![]() |
| 3:8:13 | Placenta | Reproduktion | |
| 3:E:1 | Hjärtmuskel | Hjärta | ![]() ![]() ![]() ![]() ![]() ![]() |
| 3:E:3 | Aorta (extra) | Kärl | ![]() ![]() ![]() |
| 3:E:8 | Tonsilla Palatina | Lymfoid | ![]() ![]() |
Boktips
Rekommenderad läsning
Junqueira's Basic Histology: Text and Atlas
Anthony L. Mescher · Standardlärobok i histologi
Wheater's Functional Histology
O'Dowd, Bell, Wright · Klassisk text- och bildatlas
Länkarna till Adlibris och Bokus är annonslänkar. Handlar du via dem kan sidan få en liten ersättning, utan extra kostnad för dig.